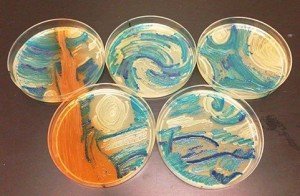
agar-art-noticias-totenart

Recibe las noticias por email
Ideas para regalar a un artista
Categorías
Comentarios recientes
- Ana Cecilia Angulo en Pintura al óleo, técnicas y características
- Javier de Mosteyrín Hernández en Las Meninas: El enigma de Velázquez
- Jeddah chat en Las 10 obras más importantes de Dalí
- Ana Cecilia Angulo en Tipos de barniz más empleados en Bellas Artes
- Ana Cecilia Angulo en 10 Obras más importantes de Joaquín Sorolla

No hay respuestas hasta ahora. Se el primero en dejar una →